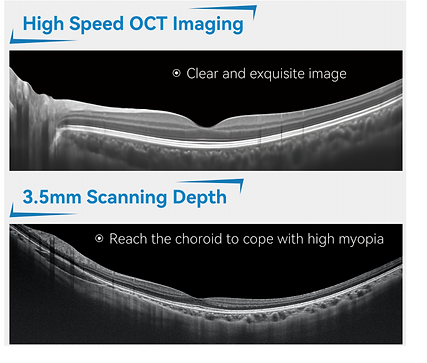
Screenshot 2025-09-27 105202.png

Tomografo de Coherencia Óptica
Luminor-D60
eL OCT Luminor-D60 es una nueva generación de tomógrafos de coherencia óptica, con funciones mejoradas, imágenes nítidas y un sistema fluido. Está equipada con software de análisis profesional que permite identificar con precisión enfermedades retinianas, apoyar en la detección y reducir los diagnósticos omitidos durante el examen inicial, lo que mejora significativamente la eficiencia en el uso clínico.
Tomografía de Coherencia Óptica Luminor-D60
El modelo Luminor-D60 de ZD Medical utiliza tecnología LSO, con una profundidad de escaneo de hasta 3.5 mm y una resolución lateral de imagen del fondo de ojo de hasta 5 μm. Equipado con software profesional de análisis, el Luminor-D60 permite visualizar claramente el grosor macular mediante el modelo de análisis de grosor macular, lo que facilita la identificación precisa de enfermedades clínicas de la mácula.
Exploración Profunda del Fondo de Ojo
La profundidad de escaneo alcanza hasta 3.5 mm, llegando a la coroides e incluso a la esclerótica, permitiendo la visualización completa de todas las capas en una sola exploración.
La profundidad de escaneo (profundidad de imagen) es uno de los parámetros de rendimiento más importantes en los sistemas OCT. El Luminor-D60 ofrece una ventaja notable en este aspecto: permite una imagen más clara de la coroides sin comprometer la resolución axial. Esto representa una ventaja significativa en el diagnóstico de enfermedades del fondo de ojo que requieren alta profundidad y alta resolución, como las patologías coroideas.

Amplio Alcance Hasta el Límite del Campo Visual
Gracias a su amplio rango de escaneo, el Luminor-D60 permite visualizar simultáneamente y con gran nitidez tanto la zona macular como el disco óptico, facilitando una evaluación integral en una sola imagen.

Modos de Escaneo
El Luminor-D60 ofrece múltiples modos de escaneo, incluyendo:
-
Escaneo de área:
Resolución de 512×64
Áreas de escaneo disponibles: 6 mm × 6 mm y 12 mm × 12 mm -
Escaneo HD de línea única:
Resolución de 1024×30 con longitud de 6 mm
Resolución de 2048×30 con longitud de 12 mm -
Escaneo multilínea:
-
Escaneo paralelo de 5 líneas
-
Escaneo en radiación
-
Escaneo circular
Análisis de Glaucoma
Mide con precisión el grosor retiniano alrededor de la fóvea y lo compara con datos normales según la edad, permitiendo analizar desviaciones en el grosor retiniano del paciente. Esto ayuda a los especialistas a diagnosticar el glaucoma de forma más certera.
Realiza un escaneo circular alrededor de la papila óptica, cuantifica automáticamente el grosor del nervio óptico y lo compara con la base de datos, facilitando la detección de atrofia del nervio óptico como signo temprano de glaucoma

Seguimiento: Gestión del Paciente Más Eficiente
El escaneo preciso y rápido permite monitorear los cambios en la enfermedad, haciendo el diagnóstico más ágil y eficaz.
El Luminor-D60 puede registrar automáticamente la posición actual de escaneo de la mácula y el globo ocular, y localizar de forma inteligente la posición previa en exámenes de seguimiento posteriores, garantizando que ambas exploraciones se realicen en el mismo punto. Basado en el análisis de tendencia del grosor retiniano en distintas etapas, permite realizar seguimientos a largo plazo y análisis evolutivos.

Examen del Segmento Anterior
Escaneo de Córnea
Escaneo en alta definición (HD), con combinación de múltiples imágenes para obtener una visualización optimizada y una estructura corneal claramente definida.
Medición automática y manual del grosor de cada capa de la córnea.
Imagen del Fondo de Ojo
El Luminor-D60 captura imágenes nítidas y detalladas del fondo de ojo, facilitando el diagnóstico preciso de diversas patologías oculares.


